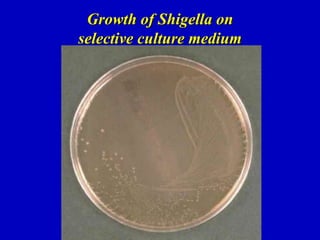
Growth of Shigella on
selective culture medium

Shigellosis is a bacterial infection caused by Shigella bacteria that is transmitted through the fecal-oral route. It causes acute bloody diarrhea and abdominal cramps. There are four species of Shigella that can cause disease with varying levels of severity. Complications can include toxic megacolitis, intestinal perforation, and hemolytic uremic syndrome. Diagnosis is made through stool culture. Treatment involves rehydration and antibiotic therapy with fluoroquinolones or sulfonamides depending on severity. Preventing transmission through proper hygiene is important for controlling outbreaks of this infectious disease.

![HUS
is a nonimmune (Coombs test–negative) hemolytic anemia
defined by a diagnostic triad:
- microangiopathic hemolytic anemia (hemoglobin level
typically <80 g/L [<8 g/dL]),
- thrombocytopenia (mild to moderate in severity;
typically <60,000 platelets/μL),
- acute renal failure due to thrombosis of the
glomerular capillaries (with markedly elevated
creatinine levels).
Anemia
is severe, with fragmented red blood cells (schizocytes) in
the peripheral smear,
high serum concentrations of lactate dehydrogenase
free circulating hemoglobin,
elevated reticulocyte counts.](https://image.slidesharecdn.com/shigellosisenglishversion-230425084953-7291c9fb/85/Shigellosis-English-version-ppt-40-320.jpg)











